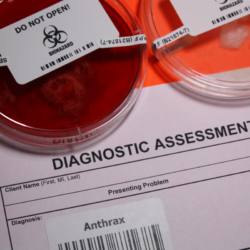
résultat de diagnostique à l'anthrax

La brucellose, une zoonose bactérienne d’importance mondiale, suscite un intérêt croissant en raison de ses répercussions sur la santé publique, la santé animale et l’économie. Cette maladie est causée par les bactéries du genre Brucella. Elle peut se transmettre de manière directe ou indirecte entre les animaux et les humains. Cette infection concerne particulièrement les ruminants domestiques et sauvages, ainsi que les suidés. En plus de causer des pertes économiques importantes chez les éleveurs, la brucellose peut entraîner des complications sévères chez l’homme. Les symptômes peuvent aller de fièvres intermittentes à des complications ostéo-articulaires graves dans les cas chroniques.
Quel est l’agent infectieux ?
La brucellose est une zoonose causée par les bactéries du genre Brucella. Cette maladie, présente à l’échelle mondiale, peut affecter à la fois les humains et la plupart des espèces de mammifères, en particulier les ruminants domestiques et sauvages, ainsi que les suidés tels que les porcs et les sangliers. Les Brucella spp sont des bactéries gram-négatives, de très petite taille (0,5-0,7 x 0,6-1,5 µm), immobiles, non encapsulées, non sporulées, aérobies strictes et facultativement intracellulaires.
Plusieurs espèces de Brucella sont pathogènes pour l’homme, notamment B. melitensis, B. abortus bovis, B. suis et accessoirement B. canis.
Les Brucella sont capables de survivre longtemps dans l’environnement extérieur, avec une durée de vie variant selon les conditions. Elles peuvent vivre jusqu’à 32 jours dans des milieux secs et non organiques, plus de 125 jours dans des milieux organiques humides et jusqu’à 135 jours dans des milieux organiques secs. Dans le sang conservé à +4 °C, elles peuvent survivre jusqu’à 180 jours.
Les ruminants domestiques, en particulier les ovins et les caprins, constituent le principal réservoir de brucellose humaine. Les bovins sont principalement infectés par Brucella abortus, tandis que les porcs sont affectés par Brucella suis.
La brucellose est classée au niveau 3 de danger biologique en France. Elle est considérée comme un agent potentiel de bioterrorisme aux États-Unis. Son mécanisme pathogène reste mal compris. En revanche, on sait qu’il implique une dissémination dans les ganglions lymphatiques et les organes du système réticulo-endothélial. De plus, cette bactérie peut échapper au système immunitaire en se développant à l’intérieur des cellules phagocytaires. Chez les animaux, les Brucella présentent un tropisme particulier pour le placenta. Cela peut entraîner des complications graves, notamment la mort fœtale.
Comment la maladie se manifeste-elle chez l’animal ?
La brucellose, une zoonose bactérienne d’importance mondiale, affecte un large éventail d’espèces de mammifères. Les bactéries du genre Brucella, notamment B. abortus, B. melitensis, B. suis et B. canis, ciblent principalement les bovins, les petits ruminants, les porcs, les sangliers, les lièvres et les chiens. Les manifestations de la maladie varient selon les espèces. Elles incluent généralement des avortements, des troubles de la reproduction et des lésions articulaires.
Chez les animaux, les brucelloses sont souvent asymptomatiques mais peuvent entraîner des avortements. Les brucelles, agents pathogènes de la maladie, ont une affinité particulière pour les organes génitaux. Cela facilite leur transmission à travers le lait ou lors de contacts sexuels. Chez les bovins, par exemple, la brucellose peut persister pendant des années dans les ganglions lymphatiques sans déclencher de symptômes immédiats. En revanche, elle peut conduire à des avortements tardifs chez les femelles gestantes.
La maladie confère une immunité partielle, bien que certains individus puissent continuer à avorter ou à produire une descendance de qualité inférieure. La transmission se fait principalement par voie sexuelle chez les porcs et les petits ruminants. Chez les chiens, elle peut provoquer de la fièvre, des avortements tardifs et des lésions testiculaires chez les mâles.
Chez les animaux domestiques, la brucellose peut entraîner des pertes économiques importantes en raison de la réduction de la fertilité et des avortements. La prévention de la maladie implique des mesures de biosécurité strictes. Elles comprennent des programmes de dépistage et de vaccination, notamment chez les troupeaux destinés à la reproduction. Une compréhension approfondie de l’épidémiologie et des manifestations cliniques de la brucellose est essentielle pour mettre en œuvre des stratégies efficaces de contrôle et de gestion de cette maladie infectieuse.
Comment se transmet la Brucellose ?
Les animaux adultes brucelliques peuvent excréter la bactérie toute leur vie dans le lait, l’urine, les sécrétions génitales. Cette excrétion est maximale au moment de l’avortement ou de la mise bas. La transmission de la mère au fœtus ou au nouveau-né est possible. La contamination de l’environnement (locaux d’élevage, pâturages…) et la conservation de jeunes femelles nées de mère infectée (5 à 10% hébergent des brucelles) sont à l’origine d’une résurgence de la maladie dans les cheptels assainis.
La brucellose se propage généralement au moment de la reproduction et lors de l’avortement ou de la mise bas. On trouve des concentrations élevées de bactéries dans les produits d’avortements et les eaux fœtales provenant d’un animal infecté. Les bactéries peuvent survivre pendant plusieurs mois hors de l’organisme de l’animal. Elle survit principalement dans le milieu extérieur, en particulier dans des conditions froides et humides. Ces bactéries dans l’environnement restent une source d’infection pour les autres animaux qui s’infectent par contact proche (voie respiratoire ou conjonctivale voire par ingestion). Les bactéries peuvent aussi coloniser le pis et contaminer le lait.
La contamination de l’homme s’opère de différentes manières. Le plus souvent, la transmission à l’homme se produit par ingestion de produits laitiers frais (lait cru) provenant d’animaux infectés par la bactérie. Elle peut aussi se produire par contact avec des animaux ayant la brucellose. Il s’agit surtout du cas des éleveurs, des vétérinaires et du personnel des abattoirs exposés à l’infection en manipulant les animaux infectés, les avortons et les placentas. La manipulation de fumier ou d’autres produits souillés, l’ingestion de légumes provenant de sols traités avec du fumier ou encore l’inhalation de poussières de litières souillées peuvent aussi contaminer l’homme.
Quels sont les symptômes chez l’Homme ?
Les symptômes et évolutions de la brucellose varient selon les formes d’infection et les stades de la maladie. Les formes les plus fréquentes, principalement avec B. abortus, se manifestent comme des formes mineures ressemblant à une grippe. Trois formes sont observées :
- La forme aiguë septicémique (ou fièvre de Malte) se caractérise par une fièvre ondulante, notamment nocturne, avec sueurs et douleurs, durant environ 15 jours après une période d’incubation de 8 à 21 jours.
- La forme subaiguë ou localisée peut affecter n’importe quel organe comme les testicules, le cœur, les poumons, les articulations, etc.
- La forme chronique, sans fièvre, se caractérise par une grande fatigue et des douleurs ostéo-articulaires.
Chez les femmes enceintes, la brucellose aiguë peut entraîner un avortement ou un accouchement prématuré. La primo-infection peut être asymptomatique ou se manifester par des symptômes légers et passer inaperçue. Par la suite, l’infection peut demeurer silencieuse pendant plusieurs mois voire années avant de se réactiver. La maladie chez l’homme présente des signes non spécifiques allant de la fièvre isolée ou du syndrome pseudo-grippal banal à des infections localisées telles que des arthrites, des orchites ou des méningites.
Les complications de la brucellose sont rares mais peuvent inclure une endocardite bactérienne subaiguë, une neurobrucellose (méningite, encéphalite, névrite), une orchite, une cholécystite, des suppurations hépatiques et une ostéomyélite. La maladie peut évoluer vers une forme chronique. Cette dernière se caractérise par une asthénie persistante et des foyers suppurés d’évolution lente. Cela représente une lourde charge pour le patient en termes de santé et de qualité de vie.
Quelques données épidémiologiques
La brucellose est une maladie répandue à l’échelle mondiale, mais sa prévalence varie selon les régions. En France, la fréquence des cas est généralement faible, avec seulement 25 cas diagnostiqués en 2003 en France métropolitaine et 2 en Nouvelle-Calédonie. La plupart des cas sont liés à des contaminations survenues à l’étranger, notamment dans les pays méditerranéens, où la maladie est plus répandue. Les voyageurs peuvent être infectés en consommant des fromages ou des produits laitiers locaux contaminés.
La situation de la brucellose en France a évolué au fil du temps. Depuis 2005, la France est officiellement déclarée indemne de brucellose bovine selon la réglementation européenne. Cependant, quelques foyers de brucellose bovine ont été identifiés en 2012, ce qui souligne la nécessité d’une vigilance continue. De plus, l’infection brucellique chez les suidés, notamment les porcs et les sangliers, a réapparu en 1993. Cela a entraîné la découverte de nombreux foyers depuis lors.
Concernant la brucellose humaine en France, la majorité des cas sont importés. Ils surviennent chez des personnes ayant séjourné dans des pays où la maladie animale est présente et mal maîtrisée. En 2017, sur 32 cas déclarés, la plupart ont été importés, principalement en provenance d’Algérie, de Tunisie et du Liban. Les cas autochtones sont devenus rares. On compte moins de 1 cas par million de personnes et par an depuis les années 2000.
La brucellose reste une préoccupation majeure pour la santé publique. Elle nécessite une surveillance continue et des mesures de contrôle efficaces pour prévenir sa propagation, en particulier dans les zones où elle est endémique.
Quelles sont les répercussions de cette zoonose ?
Les activités professionnelles à risque de contracter la brucellose comprennent le travail direct avec des animaux infectés ou leur environnement contaminé. Cela concerne notamment les éleveurs, les vétérinaires, les ouvriers d’abattoir et les personnels des laboratoires vétérinaires. En effet, ces derniers s’avèrent exposés lors de mises bas, d’avortements ou de manipulations de carcasses. En raison de son impact économique et de sa menace pour la santé, les autorités sanitaires nationales et internationales surveillent de près la brucellose. Le laboratoire Anses de santé animale de Maisons-Alfort est une référence en la matière. Il fournit expertise et conseils techniques aux États membres, avec le soutien de l’OMS pour la gestion de la brucellose chez les humains et les animaux.
Actions de l’ANSES
Le laboratoire Anses de santé animale de Maisons-Alfort est un centre de référence national, européen, OMSA et FAO pour les brucelloses animales. Il représente aussi un centre national de référence pour la brucellose humaine. Il joue un rôle clé dans la surveillance des animaux et des cas humains en France. Ce centre coordonne les activités d’un réseau de laboratoires nationaux et européens. Il contribue également à l’élaboration de stratégies de prévention, de surveillance et d’éradication. Il collabore donc de manière étroite avec les organismes sanitaires nationaux et internationaux.
Les recherches menées à l’Anses visent à améliorer les outils de diagnostic de l’infection chez les animaux et les humains, ainsi que les connaissances épidémiologiques de la brucellose dans toutes les espèces sensibles, domestiques et sauvages.
Suite à la détection de la brucellose chez certains individus, l’Anses a élaboré depuis 2013 plusieurs expertises sur les populations de bouquetins dans le massif du Bargy. L’objectif est de limiter les risques de contamination des animaux domestiques et de favoriser l’extinction naturelle de la maladie dans la population sauvage.
La stratégie recommandée par l’Agence repose sur une combinaison de captures et de tirs ciblés sur les animaux les plus à risque d’être infectés et de transmettre la maladie. Cette approche permet de :
- surveiller le niveau d’infection des bouquetins,
- de lutter contre l’infection en euthanasiant les animaux infectés,
- et de marquer les individus non porteurs du pathogène avant de les relâcher.
Cette stratégie est jugée préférable à un abattage massif des bouquetins. En effet, cela éliminerait un grand nombre d’individus sains. De plus, cette méthode rendrait difficile la surveillance et la détection d’une reprise éventuelle ou d’une dispersion de l’infection dans d’autres territoires.
Actions de l’OMS
L’OMS joue un rôle crucial dans la lutte contre la brucellose. Elle fournit des conseils techniques. Elle élabore également des normes et des orientations pour sa prise en charge. Ces conseils sont destinés aux États Membres afin de les aider à mettre en place des mesures efficaces de prévention, de surveillance et de traitement de la maladie.
Une des priorités de l’OMS est de promouvoir la coordination entre les secteurs de la santé publique et de la santé animale. Cette collaboration est essentielle pour une réponse intégrée et cohérente face à la brucellose. Elle prend en compte des interactions entre la santé humaine, animale et environnementale.
En partenariat avec d’autres organisations telles que la FAO, l’OIE et le Programme méditerranéen de lutte contre les zoonoses, l’OMS renforce les capacités des pays dans la prévention et la gestion de la brucellose. Cette collaboration se matérialise notamment à travers le système mondial d’alerte rapide et d’intervention pour les maladies animales. Ce dernier permet un partage rapide d’informations et une action concertée pour contrôler la propagation de la maladie.
Statut de la maladie
Comment peut-on diagnostiquer cette maladie ?
La brucellose se manifeste généralement par des symptômes similaires à ceux de la grippe, notamment de la fièvre, de l’asthénie, un malaise et une perte de poids. Cependant, elle peut également revêtir diverses formes atypiques, ce qui rend parfois son diagnostic difficile. La période d’incubation de la maladie varie de 1 semaine à 2 mois, mais elle est généralement de 2 à 4 semaines.
Le diagnostic de la brucellose repose sur plusieurs méthodes, notamment les hémocultures, les cultures de moelle osseuse et de liquide céphalorachidien, ainsi que les tests sérologiques de phase aiguë et convalescente. Détecter la présence de la bactérie nécessite des hémocultures, mais leur croissance peut prendre plus de 7 jours, et les prélèvements doivent pouvoir se conserver pendant plusieurs semaines. On peut également effectuer des tests sérologiques. Cependant, ils ne sont pas fiables pour toutes les espèces de Brucella, en particulier B. canis.
Le diagnostic positif implique des examens biologiques et bactériologiques spécifiques, ainsi que des tests sérologiques. On peut détecter la présence de foyers infectieux par des prélèvements au niveau des zones touchées. Le diagnostic moléculaire par PCR peut également être réalisé pour détecter la présence de l’agent pathogène.
Le diagnostic différentiel de la brucellose doit être établi en tenant compte des symptômes et des résultats des tests, afin d’exclure d’autres maladies telles que la fièvre Q, la yersiniose, ou encore les infections virales comme la primo-infection à cytomégalovirus ou la fièvre typhoïde.
Quel est le traitement en cas de contamination ?
Le traitement de la brucellose nécessite une approche multifacette. Outre l’administration d’antibiotiques spécifiques pendant plusieurs semaines, on conseille une limitation de l’activité pendant les phases aiguës, avec un repos au lit pendant les épisodes fébriles. Les douleurs musculosquelettiques sévères peuvent nécessiter des antalgiques. L’endocardite à Brucella peut nécessiter une intervention chirurgicale en complément de l’antibiothérapie.
Les antibiotiques doivent être administrés en association pour réduire les risques de récidive, avec des protocoles spécifiques en fonction de la gravité et de la présentation de la maladie. On recommande une surveillance clinique et des mesures des titres sérologiques pendant au moins un an après le traitement, car environ 5 à 15% des patients peuvent rechuter.
Il faut initié rapidement le traitement antibiotique pour éviter une infection chronique. On utilise généralement les tétracyclines en association avec des aminosides. Pour les formes sévères, l’OMS recommande une bithérapie à base de rifampicine et de doxycycline. La réalisation d’un antibiogramme n’est pas nécessaire en raison de la sensibilité élevée des souches de Brucella aux antibiotiques recommandés.
La durée du traitement varie en fonction de la phase de la maladie, mais elle peut se prolonger en cas de brucellose chronique. Un traitement symptomatique peut être nécessaire pour soulager l’asthénie et les douleurs. Un traitement antibiotique précoce permet de réduire la durée de la phase aiguë et de prévenir les complications viscérales et ostéo-articulaires.
Comment prévenir l’infection ?
Les mesures générales de prévention comprennent des pratiques d’hygiène rigoureuses dans les élevages. Cela implique :
- le nettoyage et la désinfection réguliers des locaux et du matériel,
- le stockage approprié des déchets et des cadavres animaux.
- un dépistage sérologique régulier
- l’introduction de nouveaux animaux uniquement à partir d’élevages indemnes.
La vaccination des animaux est interdite en France en raison de son interférence avec les tests de dépistage sérologique, sauf dans certaines conditions spécifiques.
Il est impératif de sensibiliser et de former le personnel aux risques associés à la brucellose et aux mesures de prévention. Il faut mettre à leur disposition des équipements de protection individuelle adéquats et des moyens d’hygiène appropriés.
En cas d’infection avérée, des mesures strictes de lutte sont nécessaires, notamment :
- la mise sous surveillance du cheptel,
- l’isolement des animaux malades,
- la désinfection des installations et des effluents contaminés,
- et éventuellement l’abattage des animaux infectés.
Pour réduire les sources de contamination, on recommande d’éviter l’utilisation de jets d’eau à très haute pression lors du nettoyage des déjections animales. Il faut également porter des équipements de protection lors de la manipulation des animaux, des cadavres ou des déchets. Le respect des règles d’hygiène personnelle, telles que le lavage régulier des mains et le port d’équipements de protection, est également essentiel pour prévenir la transmission de la maladie.
Enfin, la pasteurisation du lait est une mesure cruciale pour prévenir la brucellose chez les humains. On recommande de consommer des produits laitiers pasteurisés. Il n’existe actuellement aucun vaccin commercialisé pour l’homme. La vigilance épidémiologique, ainsi que le respect des normes d’hygiène et de biosécurité, restent essentiels pour contrôler la propagation de la maladie.